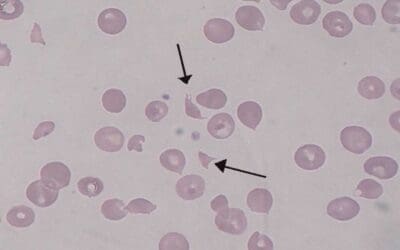
Hemolytic Uremic Syndrome (HUS)

A comprehensive guide to bone marrow failure. Learn about its causes, symptoms, diagnosis, and treatment.
Dyskeratosis Congenita
Dyskeratosis congenita (DC) is a genetic disorder causing bone marrow failure and premature aging due to short telomeres.
Diamond-Blackfan Anemia (DBA)
A rare genetic disorder, Diamond-Blackfan anemia stops the bone marrow from making enough red blood cells.
Shwachman-Diamond Syndrome (SDS)
Shwachman-Diamond Syndrome: A rare genetic disorder causing pancreatic insufficiency, neutropenia, and skeletal abnormalities.
Bone Marrow Failure
A comprehensive guide to bone marrow failure. Learn about its causes, symptoms, diagnosis, and treatment.
Diamond-Blackfan Anemia (DBA)
A rare genetic disorder, Diamond-Blackfan anemia stops the bone marrow from making enough red blood cells.
Tachycardia in Hematological Patients
Tachycardia in hematology is critical. Often signals anemia, infection, or treatment issues. Early recognition improves patient outcomes.
Liver and Causes of Hepatomegaly
Hepatomegaly means an enlarged liver, often a sign of underlying conditions like hepatitis, fatty liver, or heart failure. Diagnosis involves physical exams and imaging.
Evans Syndrome
Evans syndrome: Rare autoimmune disorder causing low red blood cells & platelets (AIHA & ITP). Can lead to fatigue, bruising, and bleeding.
Wilson’s Disease
Wilson’s disease: A rare genetic disorder causing toxic copper buildup in the liver and brain. Early diagnosis and lifelong treatment are crucial.
Hemolytic Uremic Syndrome (HUS)
Hemolytic uremic syndrome (HUS): A rare but serious condition causing red blood cell damage, low platelets, and kidney failure. Early diagnosis is key.
Hemoglobinuria: Overview and Causes
Hemoglobinuria: Red urine from free hemoglobin, not whole RBCs. Signals serious issues like hemolysis. Prompt diagnosis is vital.